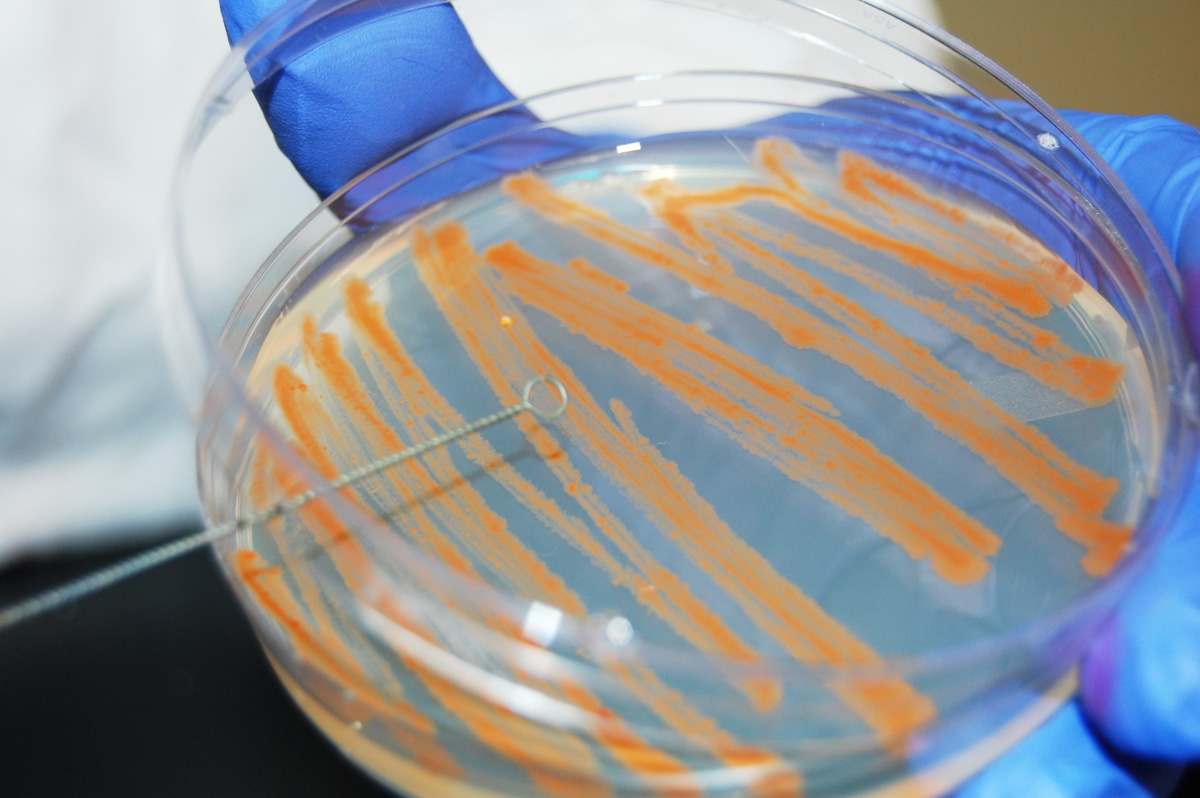

Gary E. Kaiser, Ph.D.
Professor of Microbiology
The Community College of Baltimore County, Catonsville Campus
This work is licensed under a Creative Commons Attribution 3.0 Unported License
Last updated: August, 2017
Please send comments and inquiries to Dr.
Gary Kaiser